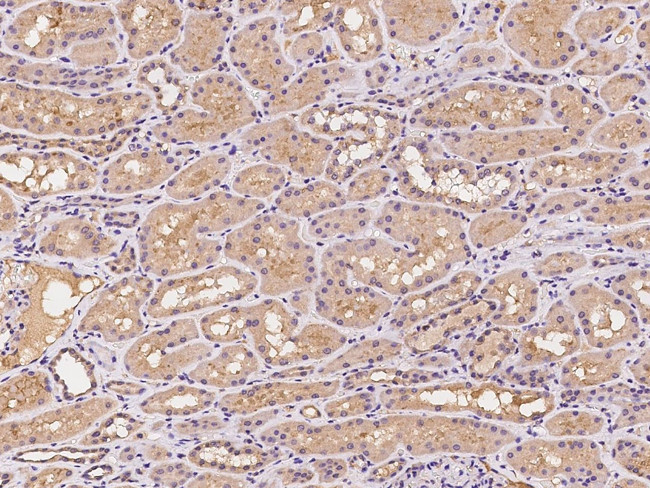
PILRB Antibody in Immunohistochemistry (Paraffin) (IHC (P))

Search
Invitrogen
PILRB Polyclonal Antibody
{{$productOrderCtrl.translations['antibody.pdp.commerceCard.promotion.promotions']}}
{{$productOrderCtrl.translations['antibody.pdp.commerceCard.promotion.viewpromo']}}
{{$productOrderCtrl.translations['antibody.pdp.commerceCard.promotion.promocode']}}: {{promo.promoCode}} {{promo.promoTitle}} {{promo.promoDescription}}. {{$productOrderCtrl.translations['antibody.pdp.commerceCard.promotion.learnmore']}}

Please note: We are reviewing Western blot images included in the antibody testing data in our catalog, including those provided by third parties. Unless expressly labeled or annotated as “raw-unedited”, Western blot images included in the antibody testing data in our catalog may have been edited, optimized or otherwise adjusted for presentation.
产品信息
PA5-148324
种属反应
宿主/亚型
分类
类型
抗原
偶联物
形式
浓度
规格
纯化类型
保存液
内含物
保存条件
运输条件
RRID
靶标信息
Paired receptors consist of highly related activating and inhibitory receptors and are widely involved in the regulation of the immune system. PILRB is thought to act as a cellular signaling activating receptor that associates with ITAM-bearing adapter molecules on the cell surface.Cell signaling pathways rely on a dynamic interaction between activating and inhibiting processes. SHP-1-mediated dephosphorylation of protein tyrosine residues is central to the regulation of several cell signaling pathways. Two types of inhibitory receptor superfamily members are immunoreceptor tyrosine-based inhibitory motif (ITIM)-bearing receptors and their non-ITIM-bearing, activating counterparts. Control of cell signaling via SHP-1 is thought to occur through a balance between PILRalpha-mediated inhibition and PILRbeta-mediated activation. These paired immunoglobulin-like receptor genes are located in a tandem head-to-tail orientation on chromosome 7. This particular gene encodes the non-ITIM-bearing member of the receptor pair, which has a truncated cytoplasmic tail relative to its ITIM-bearing partner and functions in the activating role. Alternative splicing has been observed at this locus and three variants, encoding two distinct isoforms, are described. Additional transcript variants have been identified but their full-length nature has not been determined.
仅用于科研。不用于诊断过程。未经明确授权不得转售。
篇参考文献 (0)
生物信息学
蛋白别名: Activating receptor PILR-beta; Cell surface receptor FDFACT; Paired immunoglobulin-like type 2 receptor beta
基因别名: FDFACT; PILRB; PP1551
Entrez Gene ID: (Human) 29990